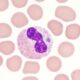
Anaplasmosis granulocitotrópica de seres humanos

La terapia holística es un enfoque terapéutico que se enfoca en tratar a la persona en su totalidad, en lugar de simplemente tratar los síntomas físicos de una enfermedad. Esta filosofía considera que la mente, el cuerpo y el espíritu están estrechamente relacionados y deben tratarse en conjunto para alcanzar la salud y el bienestar óptimos.
La terapia holística combina una variedad de técnicas y tratamientos para abordar los aspectos físicos, mentales, emocionales y espirituales de una persona. Estos pueden incluir terapias como:
- Acupuntura: Una técnica de medicina china que implica la inserción de agujas en puntos específicos del cuerpo para tratar una variedad de problemas de salud.
- Aromaterapia: El uso de aceites esenciales de plantas para promover la relajación, reducir el estrés y mejorar el bienestar emocional y físico.
- Terapia de masaje: El uso de diferentes técnicas de masaje para aliviar la tensión muscular, mejorar la circulación sanguínea, reducir el estrés y mejorar la relajación.
- Yoga y meditación: La práctica de posturas corporales, respiración controlada y meditación para mejorar la flexibilidad, reducir el estrés y mejorar el bienestar emocional y físico.
- Terapia de Reiki: Una técnica de curación basada en la creencia de que los practicantes pueden transferir energía a través de sus manos para ayudar en la curación física y emocional.
- Terapia de cristal: El uso de diferentes cristales y piedras para ayudar a equilibrar la energía del cuerpo y mejorar la salud.
El objetivo de la terapia holística es ayudar al paciente a comprender y abordar las causas subyacentes de sus problemas de salud, en lugar de simplemente tratar los síntomas superficiales. En lugar de centrarse en una enfermedad o dolencia específica, los terapeutas holísticos trabajan para mejorar el equilibrio y la armonía en todo el cuerpo, lo que se cree que conduce a una mejor salud y bienestar en general.
Además de los tratamientos físicos y emocionales, la terapia holística también puede involucrar un enfoque en la nutrición y el estilo de vida del paciente. Los terapeutas holísticos pueden recomendar cambios en la dieta, la actividad física y los hábitos de sueño para ayudar al paciente a alcanzar un mayor equilibrio y bienestar.
La terapia holística es vista por muchos como una alternativa natural y no invasiva a la medicina convencional. Sin embargo, es importante tener en cuenta que la terapia holística no es una cura para todas las enfermedades y no debe utilizarse como sustituto de la atención médica profesional. En lugar de ello, puede ser una adición útil y complementaria a otros tratamientos médicos.